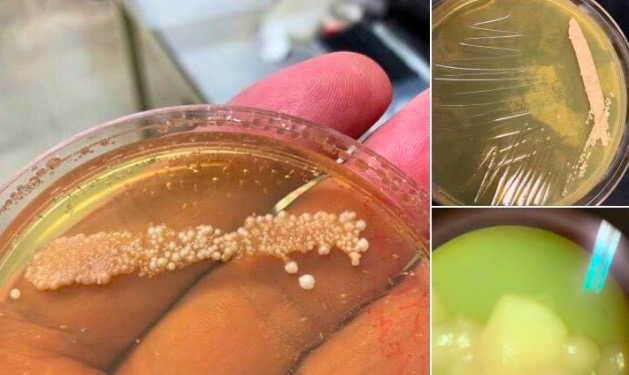

话说现在有不少人都入过烘焙的坑,
烤面包、烤饼干、烤蛋挞…反正是在坑里越陷越深,
他们从最初级阶段一路升级,尝试各种复杂的配方和做法,在烘焙路上越走越远…
而Seamus Blackley就是这样的一位烘焙爱好者~
Blackley的名字可能大家不太熟悉,他的主业是视频游戏设计,电视游戏机Xbox就是在他的主导下设计研发的。同时他也是高能物理学方面的专家,也就是说他是位物理学家。
除了主业外,Blackley的爱好是烤面包。要说烤面包也没啥稀奇的,可是他烤的面包可不太一样。
大家先来感受一下~

看起来有点粗糙…有点原始?
这就对啦~因为Blackley是不折不扣的古法自然烤面包爱好者。
有多古法多自然呢?
要想做这一款面包,首先,酵母菌需要在野外采集,

然后,培养基需要在野外制作,

其次,面粉选用的是路边种植现场研磨的有机硬质红色小麦粉,

接着,搅拌,加水~静静的等着…发酵,再做成面团,

是不是充满了大自然的原始气息?
Blackley显然对这一方法相当满意,他陆陆续续做过多款野生酵母面包,不过,渐渐地Blackley有些疲惫了,既然是古法制作面包,可是自己的这些原材料还是不够古老啊,有什么办法还原古时候人们吃的面包口味呢?
除了做面包,Blackley还是位不折不扣的古埃及文化粉,他发现古埃及人也喜欢吃面包。
那么,可不可以从古埃及出土的文物里弄点微生物弄成食用的酵母,然后做一个古埃及面包呢?
本着科学家实事求是坚持不懈的科研精神,Blackley真的开始干了。可是,摆在面前的有两个问题,
首先,自己是一个物理学家,不是生物学家,怎么样才能做到在文物上提取微生物而又不破坏文物呢?
其次,也是最重要的一点,怎么才能搞到古埃及的文物啊??
不过,上天永远不会断了一个美食爱好者吃货的路,幸运的Blackley很快得到了一位微生物学家Richard Bowman和一位古埃及学家Serena Love的支持。于是,古埃及面包制作就这样拉开了帷幕~
古埃及学家给Blackley提供了几家博物馆和研究机构收藏的藏品,允许Blackley进行采样。同时,她还帮助鉴定了这些文物中哪些更可能含有活菌。

提取微生物的过程也不算很艰难,因为微生物学家Bowman研发了一种非侵入性的提取技术。但是,前期过程需要大量设备,所以Bowman协助Blackley做了一个采样包,包括无菌的采样液和无菌的所有东西。
他们一行人来到了波士顿的艺术博物馆,见到了4500年前的古埃及文物,

顺利地提取了微生物样本,
然后快递到了Bowman的实验室进行分析研究。在这里,他们要分析出哪些微生物是现代的,哪些是古代的,还有哪些是被污染了的…
Blackley也没闲着,他把早上买的Khorasan小麦研磨成面粉,这是古埃及时期食用的小麦噢~
研磨好的面粉要高温烘烤30分钟,微生物进行进行提取分离,
对于提取出来的微生物,也要经过紫外线杀菌和高压灭菌等过程,混合面粉~

酵母加了水和没有过滤的橄榄油~做成了漂亮的面团~

叮咚,烤好了~

据Blackley说,4500年前酵母做的面包更香甜,味道更丰富!
切开看一下~

Blackley的老婆成了第一个吃螃蟹的人,据老婆说,4500年前的古埃及面包真的很美味~不过,Blackley并不是第一个从古文物上提取微生物的人。
在今年5月份的时候,一个研究小组在5000年前的古埃及容器里提取酵母酿造了啤酒。
这个研究小组来自以色列的耶路撒冷希伯来大学,他们在装啤酒和蜂蜜酒的罐子里提取了微生物菌,然后聘请了酿酒专家,用复活的酵母酿造了啤酒。
来自希伯来大学的Ronen Hazan认为,最神奇的地方就是酵母群在容器中居然存活了数千年。至于酿出来的啤酒味道,也是很不错的~
看来,烘焙有时候也是需要科研的力量。
当科学家入了烘焙的坑,做出的美食也是不一般啊~
编辑:金婉霞
责任编辑:任荃
来源:综合自英国那些事儿、CNET新闻等